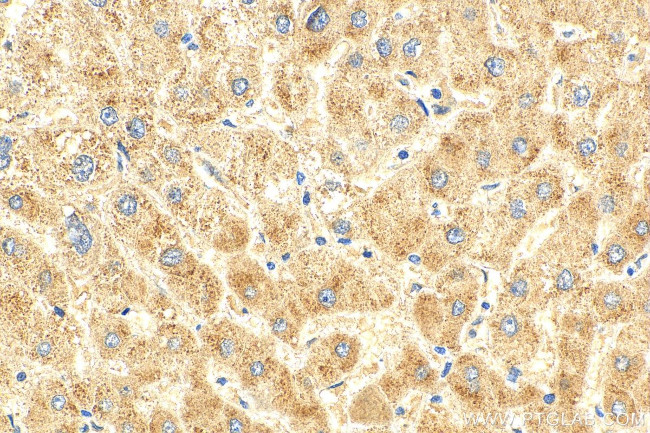
SPG7 Antibody in Immunohistochemistry (Paraffin) (IHC (P))

Search
Proteintech
SPG7 Polyclonal Antibody
{{$productOrderCtrl.translations['antibody.pdp.commerceCard.promotion.promotions']}}
{{$productOrderCtrl.translations['antibody.pdp.commerceCard.promotion.viewpromo']}}
{{$productOrderCtrl.translations['antibody.pdp.commerceCard.promotion.promocode']}}: {{promo.promoCode}} {{promo.promoTitle}} {{promo.promoDescription}}. {{$productOrderCtrl.translations['antibody.pdp.commerceCard.promotion.learnmore']}}
产品信息
27801-1-AP150UL
种属反应
宿主/亚型
分类
类型
偶联物
形式
浓度
规格
纯化类型
保存液
内含物
保存条件
运输条件
靶标信息
This gene encodes a mitochondrial metalloprotease protein that is a member of the AAA family. Members of this protein family share an ATPase domain and have roles in diverse cellular processes including membrane trafficking, intracellular motility, organelle biogenesis, protein folding, and proteolysis. Mutations in this gene cause autosomal recessive spastic paraplegia 7. Two transcript variants encoding distinct isoforms have been identified.
仅用于科研。不用于诊断过程。未经明确授权不得转售。
篇参考文献 (0)
生物信息学
蛋白别名: cell adhesion regulator; Cell matrix adhesion regulator; Mitochondrial inner membrane m-AAA protease component paraplegin; Paraplegin; spastic paraplegia 7 (pure and complicated autosomal recessive); Spastic paraplegia 7 protein; SPG7, paraplegin matrix AAA peptidase subunit; unnamed protein product
基因别名: AI452278; AU015315; CAR; CMAR; PGN; SPG5C; SPG7
UniProt ID: (Human) Q9UQ90, (Mouse) Q3ULF4
Entrez Gene ID: (Human) 6687, (Mouse) 234847